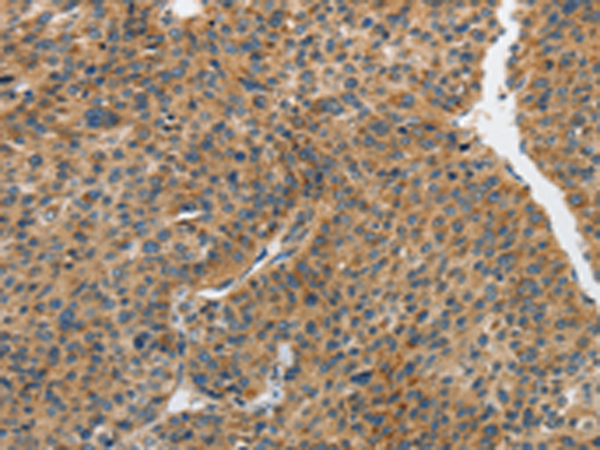

中文名稱(chēng): 兔抗PIP5K1C多克隆抗體
英文名稱(chēng): Anti-PIP5K1C rabbit polyclonal antibody
別 名: LCCS3; PIPKIg_v4; PIP5Kgamma; PIP5K-GAMMA
相關(guān)類(lèi)別: 一抗
儲(chǔ) 存: 冷凍(-20℃)
宿 主: Rabbit
抗 原: PIP5K1C
反應(yīng)種屬: Human, Mouse, Rat
標(biāo) 記 物: Unconjugate
克隆類(lèi)型: rabbit polyclonal
技術(shù)規(guī)格
|
Background: |
This locus encodes a type I phosphatidylinositol 4-phosphate 5-kinase. The encoded protein catalyzes phosphorylation of phosphatidylinositol 4-phosphate, producing phosphatidylinositol 4,5-bisphosphate. This enzyme is found at synapses and has been found to play roles in endocytosis and cell migration. Mutations at this locus have been associated with lethal congenital contractural syndrome. Alternatively spliced transcript variants encoding different isoforms have been described. |
|
Applications: |
ELISA, WB, IHC |
|
Name of antibody: |
PIP5K1C |
|
Immunogen: |
Synthetic peptide of human PIP5K1C |
|
Full name: |
phosphatidylinositol-4-phosphate 5-kinase, type I, gamma |
|
Synonyms: |
LCCS3; PIPKIg_v4; PIP5Kgamma; PIP5K-GAMMA |
|
SwissProt: |
O60331 |
|
ELISA Recommended dilution: |
2000-5000 |
|
IHC positive control: |
Human liver cancer and Human brain |
|
IHC Recommend dilution: |
25-100 |
|
WB Predicted band size: |
73 kDa |
|
WB Positive control: |
A431 and hela cells |
|
WB Recommended dilution: |
500-2000 |

購(gòu)物車(chē)
幫助
021-54845833/15800441009
